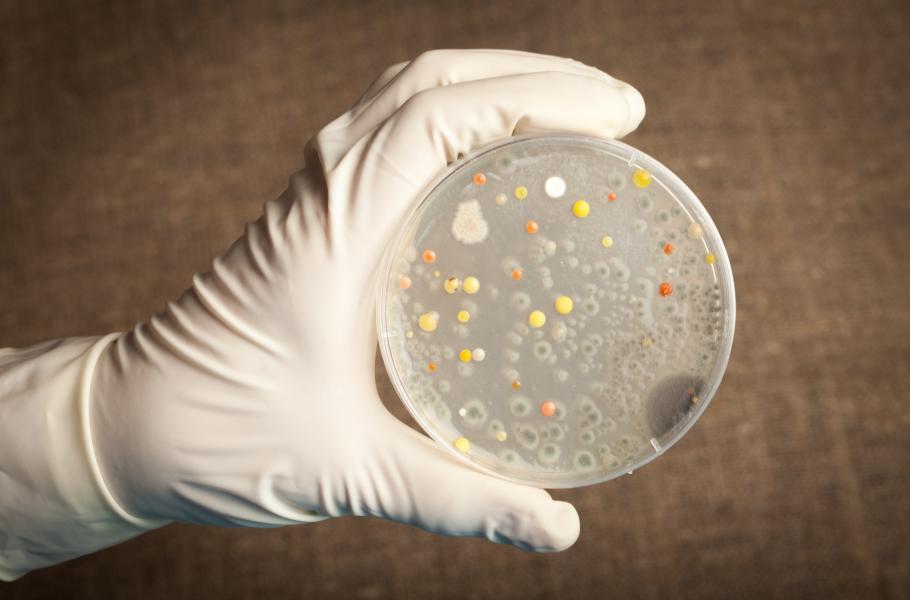

Skryté hrozby Země: Až se probudí tisíce let zmrzlé viry
Francouzští vědci zjistili, že i třicet tisíc let starý virus pohřbený pod ledem zůstává infekční. Jaká další překvapení na nás čekají v tajícím permafrostu?
Sibiřský poloostrov Jamal se zdá být prokletý. V roce 2016 tam náhle zemřel dvanáctiletý chlapec a dalších dvacet lidí museli hospitalizovat. Brzy vyšlo najevo, že se nakazili antraxem, onemocněním způsobeným bakterií Bacillus anthracis. Jedná se především o infekci divokých zvířat, neboť u lidí či skotu se ji podařilo téměř vymýtit. Jak se tedy mohlo nakazit tolik lidí naráz?
Opět jde o důsledek oteplování planety, byť nepřímý. Nejpravděpodobnější možnost zní, že se zdrojem nákazy stalo stádo 2 300 sobů, které zhruba před 75 lety poloostrovem migrovalo. Chorobě pak zvířata na Jamalu podlehla, načež jejich těla i s ničivými bakteriemi pokryl sníh a vrstva ledu. Jenže co mělo zůstat navždy pohřbené, proniklo o několik desetiletí později znovu na světlo.
Kvůli vlně horka z léta 2016, kdy teploty stoupaly až k 35 °C, roztál i jindy odolný permafrost se zkázonosnými mikroorganismy. Do kontaktu se zvířecími ostatky se pak nějak dostalo jedno z dětí místních chovatelů sobů a nemoc se začala bleskově šířit. Katastrofu odvrátila pouze rychlá reakce ruské vlády, jež do oblasti vyslala specializovanou vojenskou jednotku pro boj s biologickou nákazou – a pak také fakt, že Jamal představuje izolovaný region s minimem obyvatel.
Nákaza stále živá
Už v roce 2014 přitom francouzští vědci oživili mikroorganismus, který třicet tisíc let spočíval v hloubce tří desítek metrů v sibiřském permafrostu. Tehdy se poprvé podařilo aktivovat takto starý virus stále schopný množení. Pithovirus sibericum, jak jej badatelé nazvali, dokázal napadnout jednoduché měňavky, ale lidem ani zvířatům nebezpečný nebyl. Objevem však odborníci vztyčili varovný prst a začali se zamýšlet, co dalšího by mohl sibiřský led uchovávat.
TIP: Konec lidstva 5× jinak: Vyhladí nás geneticky upravené viry?
Odpověď přišla už o dva roky později právě na Jamalu, a to v podobě, jíž se vědci obávali. Pokud se antrax začne včas léčit antibiotiky, obvykle nekončí smrtí. Otázkou zůstává, jaké další miniaturní nebezpečí na nás v hloubce pod ledovými vrstvami číhá.